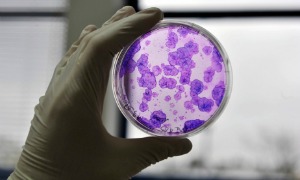

Thorium, biocarburant aux bactéries, ceinture solaire autour de la lune, pétrole de synthèse… Ces nouvelles technologies pourraient bientôt remplacer éoliennes et autres panneaux photovoltaïques !
Le thorium, une alternative crédible à l’uranium ?
Le thorium est souvent présenté comme un combustible alternatif dans la production d’énergie nucléaire. Non seulement, ce minerai est trois fois plus abondant que l’uranium mais il génère également bien moins de déchets.
Moins de déchets, plus d’énergie !
Des réserves immenses et exploitables, un volume de déchets 200 fois moins important que l’uranium… Le thorium dispose de sérieux atout. Malheureusement, il serait plus difficile à transformer… Faux ! répondent certains scientifiques. Il suffirait de le mélanger à un peu d’uranium pour que le thorium puisse être utilisé comme combustible dans les réacteurs nucléaires.

Un combustible liquide
D’autres types de réacteurs sont envisageables, comme le réacteur à sels fondus (MSFR), une piste sérieuse remarquée en 2008 lors du Forum international Génération IV. Plus stable et plus sûr, ce réacteur permettrait d’exploiter 100% de la ressource et de produire une énergie durable et écologique. Plusieurs chercheurs du CNRS de Grenoble travaillent actuellement sur ce procédé.
L’uranium fait de la résistance
Le thorium se heurte à deux obstacles majeurs : les partisans du nucléaire contestent fermement les avantages supposés de ce minerai providentiel et la France souhaite réduire la part du nucléaire dans sa production d’énergie de 75% à 50% d’ici à 2025. Un objectif peu compatible avec le développement du thorium nécessitant au contraire la relance de la filière. Mais, dans le monde, la réticence n’est pas générale : la Chine investit massivement dans ce nouvel eldorado énergétique quand l’Inde exploite déjà ses propres réserves dans des réacteurs de troisième génération.
Les formations Techniques de l’Ingénieur |
Du biocarburant truffé de bactéries
C’est une première mondiale, la société française Deinove serait parvenue à isoler et à optimiser une souche de bactéries déinocoques capable de produire de l’éthanol à partir d’une biomasse végétale industrielle à base de blé.
Un processus de fabrication simplifié
Les biocarburants de première génération (bioéthanol) étaient obtenus à partir de biomasse alimentaire et présentaient de nombreux inconvénients en termes de temps, de coût et de ressources alimentaires. Ce biocarburant deuxième génération repose entièrement sur la présence d’une bactérie, le deinocoque, qui facilite considérablement le processus en se chargeant de dégrader elle-même la biomasse et de convertir le glucose en éthanol. Résultat : une seule étape est nécessaire pour obtenir un titre en alcool de 3%.
Une bactérie particulièrement résistante
Deinocoque est capable de réparer son ADN s’il a été endommagé par des radiations et supporte de très hautes températures, ce qui a pour avantage de réduire les dépenses d’énergie lors du refroidissement des cuves. Où la trouve-t-on ? Principalement dans les sources d’eau chaude. La société Deinove a passé une convention avec le Bureau de recherches géologiques et minières (BRGM) afin de récupérer des souches partout en France.
Un développement possible dès 2014
Le directeur général de Deinove a déposé deux brevets : « l’un pour produire des biocarburants et l’autre pour de futures applications médicales ». Il a pour objectif d’obtenir une plus grande concentration en éthanol (jusqu’à 8 ou 10°) puis d’augmenter les volumes utilisés. Si le pari est réussi, il envisage le développement industriel de son procédé dès l’année prochaine.
Une ceinture solaire autour de la lune
« Luna Ring », c’est le nom de ce projet pour le moins original : une entreprise japonaise (Shimizu Corporation) a pour objectif de récupérer l’énergie du soleil en installant des panneaux solaires tout autour de la lune.
Une « ceinture » de 10 920 kilomètres
Un réseau de cellules solaires mesurant jusqu’à 40 kms entourerait l’équateur lunaire. L’énergie produite à partir de ces cellules serait transférée aux stations terrestres de réception grâce à des antennes de 20 kms de diamètre. Cette transmission serait assurée par une balise de guidage.

La construction de Luna Ring
La majorité des ressources nécessaires à la construction de la ceinture solaire serait fournie par la lune elle-même. L’eau et le ciment seraient produits à partir d’éléments constitutifs du sol lunaire quand l’hydrogène serait importé. Quant aux ouvriers, ils seraient embauchés sur Terre. Mais inutile de poser votre candidature : seuls des robots télé-opérés seraient envisagés.
Une production d’énergie illimitée
Contrairement aux panneaux photovoltaïques classiques installés sur Terre, la quantité d’énergie produite par les cellules solaires disposées autour de la lune ne dépendrait pas des variations météorologiques. Luna Ring pourrait fournir de l’énergie solaire, partout dans le monde, 24h/24 !
Du pétrole à base… d’air !
Il s’agit de capturer le dioxyde de carbone et l’hydrogène contenus dans l’air et de les transformer ensuite en méthanol, puis en carburant ! Si l’idée n’est pas nouvelle, son application est une première. Les ingénieurs britanniques qui ont accompli cet exploit sont parvenus à fabriquer un pétrole de synthèse si proche de l’original qu’il est parfaitement compatible avec nos voitures actuelles.
Comment capture-t-on l’air ?
Le CO2 et l’hydrogène sont extraits séparément. Dans un premier temps, l’air est mélangé à de l’hydroxyde de carbone, puis séparé du carbonate de sodium par électrolyse de façon à capturer le CO2. Dans un second temps, l’eau présente dans l’air est condensée et l’hydrogène est obtenu par électrolyse de l’eau.

Le CO2 enfin recyclé !
Ce procédé permettrait donc non seulement de réduire les rejets de gaz à effet de serre mais aussi de produire de l’énergie ! La solution miracle ? Pas tout à fait. L’électrolyse consomme de l’électricité. Pour que le procédé constitue une réelle avancée en termes d’efficacité énergétique, il faudrait utiliser une énergie renouvelable, comme l’éolien ou le solaire.
Une production encore insuffisante
La compagnie qui a mis au point cette technologie (Air Fuel Synthesis) a produit à peine 5 litres de carburant en trois mois. Mais elle envisage de produire d’ici deux ans une tonne de pétrole de synthèse par jour, soit sept barils. Un beau pari, même si le volume peut paraître faible en comparaison des 80 millions de barils de pétrole naturel produits quotidiennement dans le monde. Mais la promesse est de taille : produire de l’énergie à partir de notre propre pollution…
Du chauffage gratuit grâce aux supercalculateurs
Les serveurs informatiques des entreprises dégagent une chaleur phénoménale. Pourquoi ne pas exploiter cette source de chaleur pour chauffer les particuliers ? C’est l’idée de Qarnot Computing, une startup française qui envisage de créer des radiateurs électriques intégrant des processeurs.
Aucune déperdition de chaleur
Selon le directeur de Qarnot Computing, il suffirait d’installer les calculateurs directement chez les particuliers qui profiteraient de la chaleur générée. Quant aux entreprises, elles réduiraient leurs dépenses car les data-centers qui hébergent habituellement les serveurs représentent un coût important. Une grande banque européenne pourrait ainsi fournir du chauffage pour 10 000 foyers par an.

Une installation simple
Des microprocesseurs intégrés à un radiateur en aluminium et… c’est tout. L’installation chaufferait le logement tout en traitant les données des entreprises. Les bureaux de la société (300 m2) sont déjà chauffés grâce à ce procédé. Un thermostat permet de réguler la température. En cas de grand froid, il sera possible d’augmenter la chaleur en offrant la capacité de calcul non utilisée à la recherche scientifique.
Bémols…
Malgré les nombreux avantages, quelques zones d’ombre persistent. D’une part, la maintenance pourrait être difficile à assurer puisque les serveurs se trouveront disséminés chez les particuliers au lieu d’être regroupés dans un data center. D’autre part, le système ne fonctionnerait pas uniquement l’hiver, mais toute l’année : que faire de cette chaleur en pleine canicule ?
Par Iris Trahin
Découvrez les formations Techniques de l’Ingénieur : |















Réagissez à cet article
Connectez-vous
Vous avez déjà un compte ? Connectez-vous et retrouvez plus tard tous vos commentaires dans votre espace personnel.
Vous n'avez pas encore de compte ?
Inscrivez-vous !